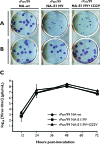

Oseltamivir-resistant influenza A viruses are transmitted efficiently among guinea pigs by direct contact but not by aerosol
- PMID: 18684820
- PMCID: PMC2566271
- DOI: 10.1128/JVI.01226-08
Oseltamivir-resistant influenza A viruses are transmitted efficiently among guinea pigs by direct contact but not by aerosol
Abstract
Influenza viruses resistant to the neuraminidase (NA) inhibitor oseltamivir arise under drug selection pressure both in vitro and in vivo. Several mutations in the active site of the viral NA are known to confer relative resistance to oseltamivir, and influenza viruses with certain oseltamivir resistance mutations have been shown to transmit efficiently among cocaged ferrets. However, it is not known whether NA mutations alter aerosol transmission of drug-resistant influenza virus. Here, we demonstrate that recombinant human influenza A/H3N2 viruses without and with oseltamivir resistance mutations (in which NA carries the mutation E119V or the double mutations E119V I222V) have similar in ovo growth kinetics and infectivity in guinea pigs. These viruses also transmit efficiently by the contact route among cocaged guinea pigs, as in the ferret model. However, in an aerosol transmission model, in which guinea pigs are caged separately, the oseltamivir-resistant viruses transmit poorly or not at all; in contrast, the oseltamivir-sensitive virus transmits efficiently even in the absence of direct contact. The present results suggest that oseltamivir resistance mutations reduce aerosol transmission of influenza virus, which could have implications for public health measures taken in the event of an influenza pandemic.
Figures

References
-
- Abed, Y., M. Baz, and G. Boivin. 2006. Impact of neuraminidase mutations conferring influenza resistance to neuraminidase inhibitors in the N1 and N2 genetic backgrounds. Antivir. Ther. 11971-976. - PubMed
-
- Baz, M., Y. Abed, J. McDonald, and G. Boivin. 2006. Characterization of multidrug-resistant influenza A/H3N2 viruses shed during 1 year by an immunocompromised child. Clin. Infect. Dis. 431555-1561. - PubMed
-
- Centers for Disease Control and Prevention. FluView: 2007-2008 influenza season week 20, ending May 17, 2008. Centers for Disease Control and Prevention, Atlanta, GA. http://www.cdc.gov/flu/weekly/index.htm. Accessed 5 June 5 2008.
-
- Colman, P. M., J. N. Varghese, and W. G. Laver. 1983. Structure of the catalytic and antigenic sites in influenza virus neuraminidase. Nature 30341-44. - PubMed
Publication types
MeSH terms
Substances
Grants and funding
LinkOut - more resources
Full Text Sources
Other Literature Sources
Medical